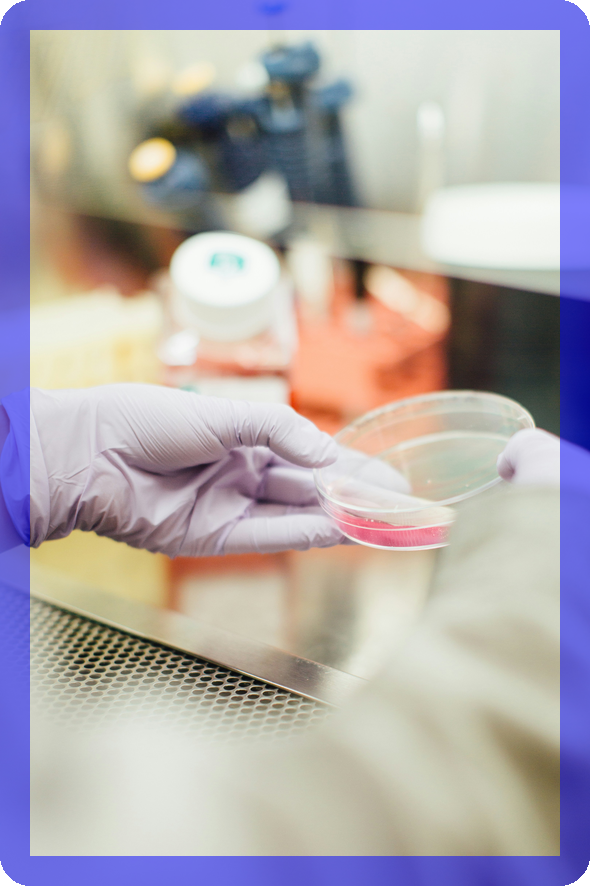

정원 확대 정책의 배경과 필요성
의과대학 정원 확대 정책은 현재 보건의료계에서 중요한 이슈로 떠오르고 있습니다. 이 정책의 추진 배경은 의사 인력 부족 현황, 고령화 사회의 의료 수요 증가, 그리고 정원 확대에 대한 사회적 요구 등으로 다각적으로 분석될 수 있습니다.
의사 인력 부족 현황
현재 한국의 의사 수는 인구 대비 매우 낮은 수준에 머물러 있어, OEDC 국가들 중 최하위를 기록하고 있습니다. 정부의 자료에 따르면, 2025년에는 추정적으로 약 2만 명의 의사가 부족할 것으로 전망되며 이는 더욱 심각한 문제로 자리 잡을 것입니다.
"향후 20년 동안 의사 수의 증가가 필요하다." - 김윤 교수
이는 단순히 수치적인 문제만이 아니라, 응급실이나 지방의료의 붕괴와 같은 현실적인 문제로 나타나고 있습니다. 의사의 수가 부족하면, 진료의 질이 저하되고, 의료 서비스의 접근성이 떨어지게 됩니다.
고령화 사회와 의료 수요 증가

대한민국은 현재 고령화 사회로 접어들고 있으며, 이는 의료 수요의 확대로 직결됩니다. 고령 인구가 증가함에 따라 만성질환과 같은 치료가 필요한 환자 수가 늘어나고 있습니다.
많은 전문가들은 고령화가 의료 수요를 더욱 초래하고 있으며, 이를 대비하기 위해서는 의과대학 정원을 확대해야 한다고 강조합니다. 특히 심혈관, 신경, 암 질환 등의 치료를 위한 인력 확보가 시급하다고 알려져 있습니다.
정원 확대의 사회적 요구

사회의 전반적인 분위기도 의사 정원 확대에 대한 강한 지지를 나타내고 있습니다. 여론 조사 결과, 대다수의 응답자가 의대 정원 확대에 찬성하고 있으며, 이는 국민들의 목소리를 명확하게 반영하고 있습니다.
누구나 의사를 찾을 수 있는 환경을 조성하기 위한 노력은 필수입니다. 이를 위해서는 정부가 정책적으로 의료 인력을 철저하게 준비하고, 사회 전체가 이 정책에 대한 정당성을 인식해야 합니다. 국민의 권리이자 정부의 의무인 의료 서비스 제공의 품질을 높이기 위해 정원 확대는 불가피한 선택입니다.
결론적으로, 의료 인력 부족 문제와 고령화 사회의 촉진에 따른 의료 수요 증가, 그리고 국민의 강력한 요구는 의과대학 정원 확대 정책을 촉진하는 주요 요인이라 할 수 있습니다. 이러한 정책이 실현된다면, 앞으로의 의료 환경은 더욱 개선될 것으로 기대됩니다.
👉정원 확대 전환점2020년과 2022년의 정책 변화
의과대학 정원 확대는 한국 의료 정책의 중심 이슈 중 하나로, 정책의 변화가 어떻게 이루어졌는지 자세히 살펴보겠습니다.
전 정부의 의대 정원 확대 추진
2020년 문재인 정부는 코로나19로 인한 의료 인력 부족을 해결하기 위해 의대 정원을 연 400명씩, 총 4000명 확대하는 방안을 제안했습니다. 이는 10년간 진행될 계획이었습니다. 그러나 의료계의 강력한 반발과 함께 집단 행동이 일어났습니다. 결국, 정책은 원점에서 재논의하기로 합의되었습니다.

의료계의 반대 및 집단 행동
의대 정원 확대에 대한 의료계의 저항은 예사롭지 않았습니다. 2020년의 집단 행동은 필요성을 갖고 인력 수급을 해결하기 위해 진행됐으나, 의협과 회원들의 우려로 인해 중요한 협의가 중단되었습니다. 대부분의 의사들은 정책의 필요성과 의사 공급 확대에 대한 강한 반대를 표출하였습니다. > "의사들이 병원에 남아야 할 이유와 환자를 위한 책임을 생각해야 합니다."
정치적 합의의 변화
2022년 12월, 윤석열 정부에서는 의대 정원 확대를 재추진하며 교육부와 보건복지부 간의 협의를 강화했습니다. 국회는 지역의사 양성을 위한 특수법안들을 마련하며 합의의 필요성을 강조하였습니다. 의료 인력의 부족은 지지하는 여론을 바탕으로 깊이게 다뤄지었습니다. 결국, 여야를 막론하고 의대 정원 증원이라는 방향으로 정치적 합의가 나아가고 있습니다.

이러한 변화들은 한국 보건 의료 시스템에 대한 지속적인 종합 검토와 적극적인 정책 결정의 중요성을 시사하고 있습니다. 의료계와 정부 간의 대화와 협의가 이루어지는 것이 필수적입니다.
👉과거 정책 비교하기2023년도 의대 정원 변화
대한민국의 의과대학 정원 변화는 의료계뿐만 아니라 국민에게도 큰 영향을 미치는 주제입니다. 2023년부터 시작된 정원 확대안은 여러 정부 정책과 사회적 요구를 반영하고 있습니다. 이 섹션에서는 정부의 의사 인력 증원 방향, 정원 확대 일정, 그리고 의료현안협의체의 합의 내용에 대해 다루어 보겠습니다.
정부의 의사 인력 증원 방향

윤석열 정부는 의사 인력 증원을 최우선 과제로 설정하고 있습니다. 2023년 5월 18일, 정부의 주요 인사들은 “의사 인력 증원은 더 이상 미룰 수 없다”는 입장을 발표하였습니다. 2025학년도 대학수학능력시험부터 의과대학의 정원을 512명 확대할 계획이 잡혀 있습니다. 이 과정에서 정부는 보건의료 정책을 시민단체와 전문가의 의견을 수렴하여 결정하는 방향으로 나아가겠다고 밝혔습니다.
“앞으로 보건의료정책심의원회를 중심으로 정책을 합의해 나가겠다.” – 정부 관계자
정원 확대 일정 및 구체적 방안

정원 확대 일정은 단계적으로 진행될 것을 예고하고 있습니다. 2023년 10월 26일, 정부는 "2025학년도 의대정원 확대 추진계획"을 발표하였으며, 각 의과대학의 수요 조사를 통해 적정 인력이 설정될 것입니다. 2025학년도부터 총 2000명의 의사가 추가로 입학할 예정이며, 이는 이상적인 의사 수를 충족하는 데 도움이 될 것으로 기대됩니다.
의료현안협의체의 합의

의료현안협의체는 정부와 의료계의 동반 성장을 도모하기 위해 구성되었습니다. 2023년 6월 26일, 보건복지부와 의사협회는 의대 정원 확대에 대한 공감대를 확인했습니다. 이는 국민의 의료 접근성을 높이고, 각 분야에서의 의료 필요를 충족하기 위한 노력이 포함되어 있습니다. 2023년 11월 22일, 협의체에서는 정부의 수요조사와 관련된 결과 발표에 대해 불만을 제기하며, 이는 향후 협의 과정에서 재검토되어야 할 사항이라고 언급하였습니다.
의대 정원 변화는 단순히 수치의 변동만이 아닌, 대한민국의 미래 의료 환경이 어떻게 변화할지를 결정짓는 중요한 요소입니다. 이러한 변화가 긍정적인 방향으로 나아가기 위해서는 정부와 의료계 간의 지속적인 소통과 협력이 필수적입니다.
👉현재 상황 파악하기2024년도 증원 추진 계획
2024년도에 의과대학 정원을 대폭 증원하기 위한 다양한 계획이 마련되고 있습니다. 이러한 계획은 향후 의료 서비스의 안정성과 질을 높이는 데 큰 기여를 할 것으로 기대됩니다. 이 글에서는 의과대학 정원 증원 규모, 정원 배정 수요조사 결과, 그리고 정부의 조정 방안에 대해 자세히 알아보겠습니다.
의과대학 정원 증원 규모

2024년 2월 1일, 정부가 의과대학 정원을 2000명 증원할 계획을 발표했습니다. 이는 현재 3058명에서 5058명으로의 확대를 의미하며, 2035년까지 최대 1만 명의 의사 인력을 확충한다는 목표를 가지고 있습니다. 이러한 증원 규모는 고령화 사회와 국민의 건강을 위한 필수 의료 제공이 과제로 떠오른 시점에서 중요한 조치입니다.
"의대 정원 증원은 국민의 의료 접근성을 높이는 중대한 결정이다." - 보건복지부 관계자
정원 배정 수요조사 결과

2024년 1월과 3월에 실시된 수요조사에 따르면, 각 의과대학은 최소 2151명에서 최대 2847명의 추가 정원 증원을 요청했습니다. 이는 의대 교육의 질을 유지하면서도 필요한 인력을 양성하는 데 필요한 최소한의 수치로 여겨집니다. 특히, 각 대학의 역량에 따라 최대 수치는 추가 교육 여건이 마련되었을 때 가능한 수치로 나타났습니다.
이같은 수요조사 결과는 향후 의대 정원 조정의 중요한 기준이 될 것입니다.
정부의 조정 방안

정부는 의과대학 정원 확대를 위해 여러 조정 방안을 마련했습니다. 2024년 하반기에는 의사 인력 수급 현황을 주기적으로 검토하고 조정하겠다는 계획이 포함되었습니다. 이 계획은 감염병 상황, 의료기술 발전, 고령화 추이 등 다양한 요소를 종합적으로 고려하여 진행될 것이며, 확인된 수요조사 결과에 기반하여 정원을 설정할 예정입니다.
결국, 미래의 한국 의료 환경을 위한 이러한 조치는 전체 국민의 건강과 직결되며, 올바른 방향으로 진행된다면 의료 서비스의 질적 향상으로 이어질 것입니다. 의료계의 협력과 이해를 바탕으로 한 이 정책이 안정적인 의료 체계로 발전하는 데 기여할 것으로 기대됩니다.
👉미래 계획 살펴보기의료계의 반응 및 사회적 논란
의과대학 정원 대폭 확대라는 정부의 정책에 대해 의료계의 반응과 사회적 논란이 점차 격화되고 있습니다. 이 정책은 필수의료 인력 부족 문제를 해결하기 위함이라지만, 이에 대한 의사 및 전공의들의 집단 행동, 의료계와 정부 간의 갈등, 그리고 여론의 변화가 함께 얽히면서 복잡한 상황을 만들어가고 있습니다.
의사 및 전공의들의 집단 행동

의사들은 정부의 의과대학 정원 확대 정책에 강력히 반발하고 있으며, 이에 따른 집단 행동을 조직하고 있습니다. 특히, 전국의사총궐기대회를 개최하며, 정원 확대 방안이 자신들의 권리를 침해한다고 주장하고 있습니다. 이들과 관련하여 한 전공의는 다음과 같이 말했습니다.
"의대 정원을 늘리면 현재의 의료 공백 현상이 해결되지 않는다. 우리는 신뢰 받는 진료를 제공할 수 있는 환경이 필요하다."
이처럼 현장에서는 의사들이 단순히 정원 증대를 반대하는 것이 아니라, 의료의 질과 환자 안전을 우선시하는 입장을 견지하고 있습니다.
의료계와 정부 간의 갈등

정부와 의료계 간의 갈등은 점점 격화되고 있습니다. 정부는 인력 부족 문제를 해결하기 위한 정원 증대의 필요성을 강조하는 반면, 의사단체는 정부의 일방적인 결정을 비판하며 팽팽한 긴장감을 유지하고 있습니다. 의협 측에서는 "하루라도 빨리 임기응변식의 해결책을 제시하라"며, 정부의 입장에 강력히 반발하고 있습니다. 이와 관련하여 보건복지부 관계자는 정부의 추진 의지를 확고히 하며 다음과 같은 입장을 밝혔습니다.
"의사의 수를 늘려야 한다는 것은 국민의 목소리입니다. 필수의료가 어떻게든 확보되어야 한다는 점에서 정부는 한 발도 물러서지 않을 것입니다."
여론의 변화와 사회적 압박

여론조사 진행 결과, 의과대학 정원 확대에 대한 국민의 지지율은 무려 89.3%에 달하는 것으로 나타났습니다. 이는 국민 대다수가 현재의 의료 인력 부족 문제를 심각하게 인식하고 있으며, 정부의 정책을 지지하고 있다는 것을 의미합니다. 여론조사 결과에 따르면, 응답자의 71.9%는 의사들의 반발에 부정적인 입장을 보였으며, 그 결과는 향후 의료 정책 결정 과정에 큰 영향을 미칠 것으로 예상됩니다.
이렇듯 현재 의료계의 논란은 복잡하게 얽혀 있으며, 다양한 구성원들이 발언권을 행사하고 있습니다. 앞으로의 상황은 더욱 지켜봐야 할 필요가 있습니다.
👉위기 속의 대응방안결론 및 향후 전망
의료 인력 부족의 문제는 점점 심각해지고 있으며, 이에 대한 향후 정책 방향과 과제는 긴급한 이슈입니다. 정부는 최근 의과대학 정원 확대를 공언했으나, 이 정책의 실행과 효과는 여전히 불확실한 상황입니다. 의사 인력의 수급 상황은 변화 흐름 속에서 지속적으로 분석되고 조정되어야 하며, 이를 위한 여러 가지 과제가 대두되고 있습니다.
향후 정책 방향과 과제

정부의 의대 정원 확대 정책은 필수의료 분야의 인력 부족 문제를 해결하기 위한 첫 단추로 보입니다. 하지만, 정책의 효과가 실제 의료 현장에서 어떻게 나타날지에 대한 불확실성이 크고, 이를 해결하기 위한 다양한 과제가 뒤따릅니다. 이에 따라, 정책 추진 시 다음과 같은 점들이 강조되어야 할 것입니다:
"의사 인력 수급의 지속 가능성을 유지하기 위해서는 정책을 실질적으로 검증하고, 지속적으로 조정하는 것이 필요하다."
의료 인력 수급의 지속 가능성

의료 인력 수급이 지속 가능한가에 대한 의문은 주목해야 할 핵심 요소입니다. 정책적으로 의료 인력을 늘리더라도, 인력의 질과 지역적 분포가 균형적으로 이루어질 수 있도록 하는 것이 중요합니다. 필요한 인력 수를 예측하고 적정 수준으로 육성하는 다양한 접근이 요구됩니다.
정부와 의료계의 협력 필요성

정부와 의료계 간의 협력은 성공적인 정책 추진의 필수 요소입니다. 정책의 수립 및 실행 과정에서 의료계의 의견을 적극 반영함으로써, 불필요한 갈등을 줄이는 한편, 정책의 효과성을 높일 수 있습니다. 다양한 의견과 정보를 공유하는 시스템이 구축되어야 하며, 이는 이후의 의료 정책과 법안에도 긍정적인 영향을 미칠 것입니다.
결국, 앞으로의 의료 정책은 의사 인력 수급을 단기적인 해결책이 아닌, 장기적으로 지속 가능한 시스템으로 발전시켜 나가야 할 것입니다. 이러한 방향성이 뒷받침된다면, 우리 사회의 의료 서비스 품질 향상은 물론, 국민의 건강권 보장에도 기여할 것으로 기대됩니다.
👉정책의 미래를 고민하다